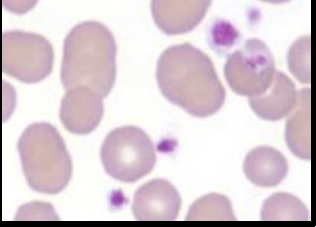
term image
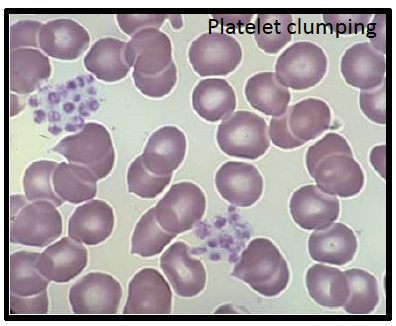
term image
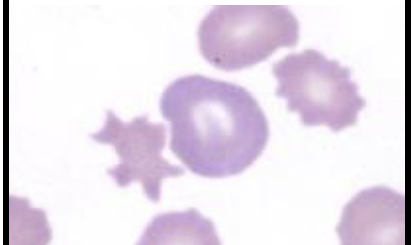
term image
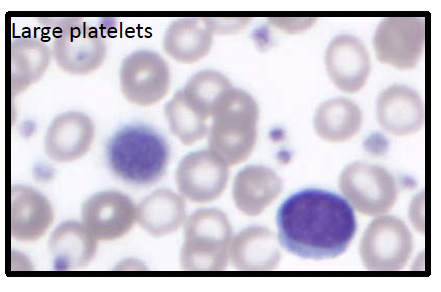
term image

WBC - CBC
1/33
There's no tags or description
Looks like no tags are added yet.
Name | Mastery | Learn | Test | Matching | Spaced | Call with Kai |
|---|
No analytics yet
Send a link to your students to track their progress
34 Terms
platelet structure:
what are the (3) types of granules?
-alpha: proteins (Fb, V, vWF, PF4, PDGF
-dense: ions (ADP/ATP, Ca, serotonin
-lysosomes (hydrolases)
summary:
Von Willebrand Factor (vWF)
-large, adhesive glycoprotein essential for blood clotting
-glue that helps platelets adhere to tissue
summary:
thrombopoietin
-glycoprotein hormone
-produced by the liver and kidneys
-master regulator of platelet production
where else is thrombopoietin made?
-spleen
-liver
-lung
(bone marrow, ofc)
most basic fx cascade
adhesion → aggregation → secretion
basic relationship:
theombopoeitin & platelets
dec in plt, inc in thrombopoietin
where are platelet clumps generally seen on blood smears?
-body
-feathered edge (particularly larger clumps)
max #:
platelets/100x oil
25-35
what is the general growth/movt of megakaryocytes?
cytoplasm → proplatlets → platelets
lifespan:
platelets
5-9 d in circhow
how are platelets removed?
-macrophages in spleen, liver
-can be used in vessel walls
how much of the spleen is circulating platelet mass?
30-40%
what (2) things can cause throbocytosis?
-adrenaline
-splenic congestion
most common cause:
thrombocytopenia
-platelet clumping
qualitative:
monolayer of blood smear
-platelet estimation
-morphologic evaluation
Qualitative:
Body of blood smear
-platelet clumps will often be found here
Qualitative:
Feathered edge of blood smear
– Large clumps of platelets will be found here
-normal platelet count
– Platelet clumping
-thrombocytopenia
-large platelets (generally more immature)
summary:
Ehrlichiosis
-tick borne
-Aus: brown tick Ehrlichia canis
-destruction of WBC/RBC/platelets
-doxycycline
causes:
thrombocytosis
-rxn: infla, blood loss, neoplasia
-splenectomy
-adrenaline
what is a RARE cause of thrombocytosis
-essential thrombocythaemia (bone marrow neoplasm)
what does a contraindication of bone marrow sampling mean?
-conditions exist that make the procedure unsafe or inadvisable because they increase the risk of serious complications
contraindication:
bone marrow sampling
-acute bleeding due to hemostatic disorder
-hemorrhage control post sample
what is not a contraindication of bone marrow sampling?
-thrombocytopenia
Went to do a bone marrow biopsy?
-if that BMA has poor cellular structure
-if the bone is of what is of interest
What is important to know about bone marrow biopsy?
-so your morphology is affected by fixation
cytology:
Bone marrow aspirate
-clinical pathology
Histopathology:
Bone marrow biopsy
-anatomic pathology
bone marrow sampling:
which is better for cell morph quality?
-BMA
bone marrow sampling:
which is better for general better quality (architecture, cellularity, iron stores)
-bone marrow biopsy
non-hematopoetic cells in bone marrow (5)
-some stromal cells
< 1% marcos
1-10% small mature lymphocytes
1% plasma cells
-rare osteoblasts & clasts